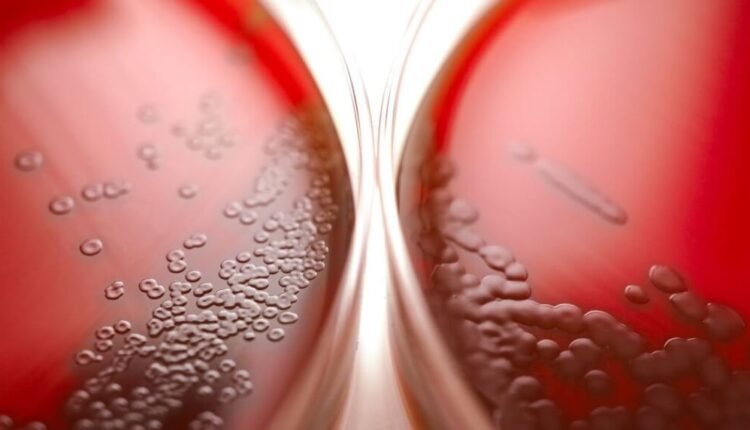
Δεν-υπάρχει-επιδημία-στρεπτόκοκκου-βεβαιώνει-ο-Πανελλήνιος-Ιατρικός-Σύλλογος

Δεν υπάρχει επιδημία στρεπτόκοκκου βεβαιώνει ο Πανελλήνιος Ιατρικός Σύλλογος

ΠΙΣ: Οι στρεπτοκοκκικές λοιμώξεις δεν συνιστούν επιδημία, ούτε πανδημία
Με αφορμή τα περιστατικά στρεπτοκοκκικών λοιμώξεων των τελευταίων ημερών ο Πανελλήνιος Ιατρικός Σύλλογος συμβουλεύει τι πρέπει να κάνουν μικρά παιδιά και ευαίσθητοι ασθενείς, όταν αντιμετωπίζουν οξέα ή επιδεινούμενα συμπτώματα. Αναφέρεται στην ορθή χρήση των τεστ ανίχνευσης του στρεπτόκοκκου και τονίζει ότι οι στρεπτοκοκκικές λοιμώξεις δεν συνιστούν επιδημία, ούτε πανδημία στη χώρα μας, όπως και διεθνώς.
Πιο συγκεκριμένα ο ΠΙΣ επισημαίνει στην ανακοίνωσή του:
Α) Οι στρεπτόκοκκοι είναι γνωστά μικρόβια για τα οποία υπάρχουν φάρμακα που τα αντιμετωπίζουν. Σπανίως, προκαλούν βαριά νόσο με τραγική κατάληξη και για το λόγο αυτό θα πρέπει μικρά παιδιά και ευαίσθητοι ασθενείς να αναζητούν έγκαιρα ιατρική συμβουλή και φροντίδα, όταν αντιμετωπίζουν οξέα ή επιδεινούμενα συμπτώματα.
Οι στρεπτοκοκκικές λοιμώξεις δεν συνιστούν επιδημία, ούτε πανδημία στη χώρα μας, όπως και διεθνώς.
Β) Τα τεστ ανίχνευσης του στρεπτόκοκκου, καίτοι πωλούνται από τα φαρμακεία, δεν προορίζονται για χρήση από τους ασθενείς. Για την αξιόπιστη χρήση τους και διάγνωση της λοίμωξης πρέπει να διενεργούνται από τον κλινικό ή εργαστηριακό γιατρό ή εξειδικευμένο λειτουργό υγείας.
Επίσης θα πρέπει να γίνονται κατόπιν ιατρικών οδηγιών.

Τα σχόλια είναι κλειστά.